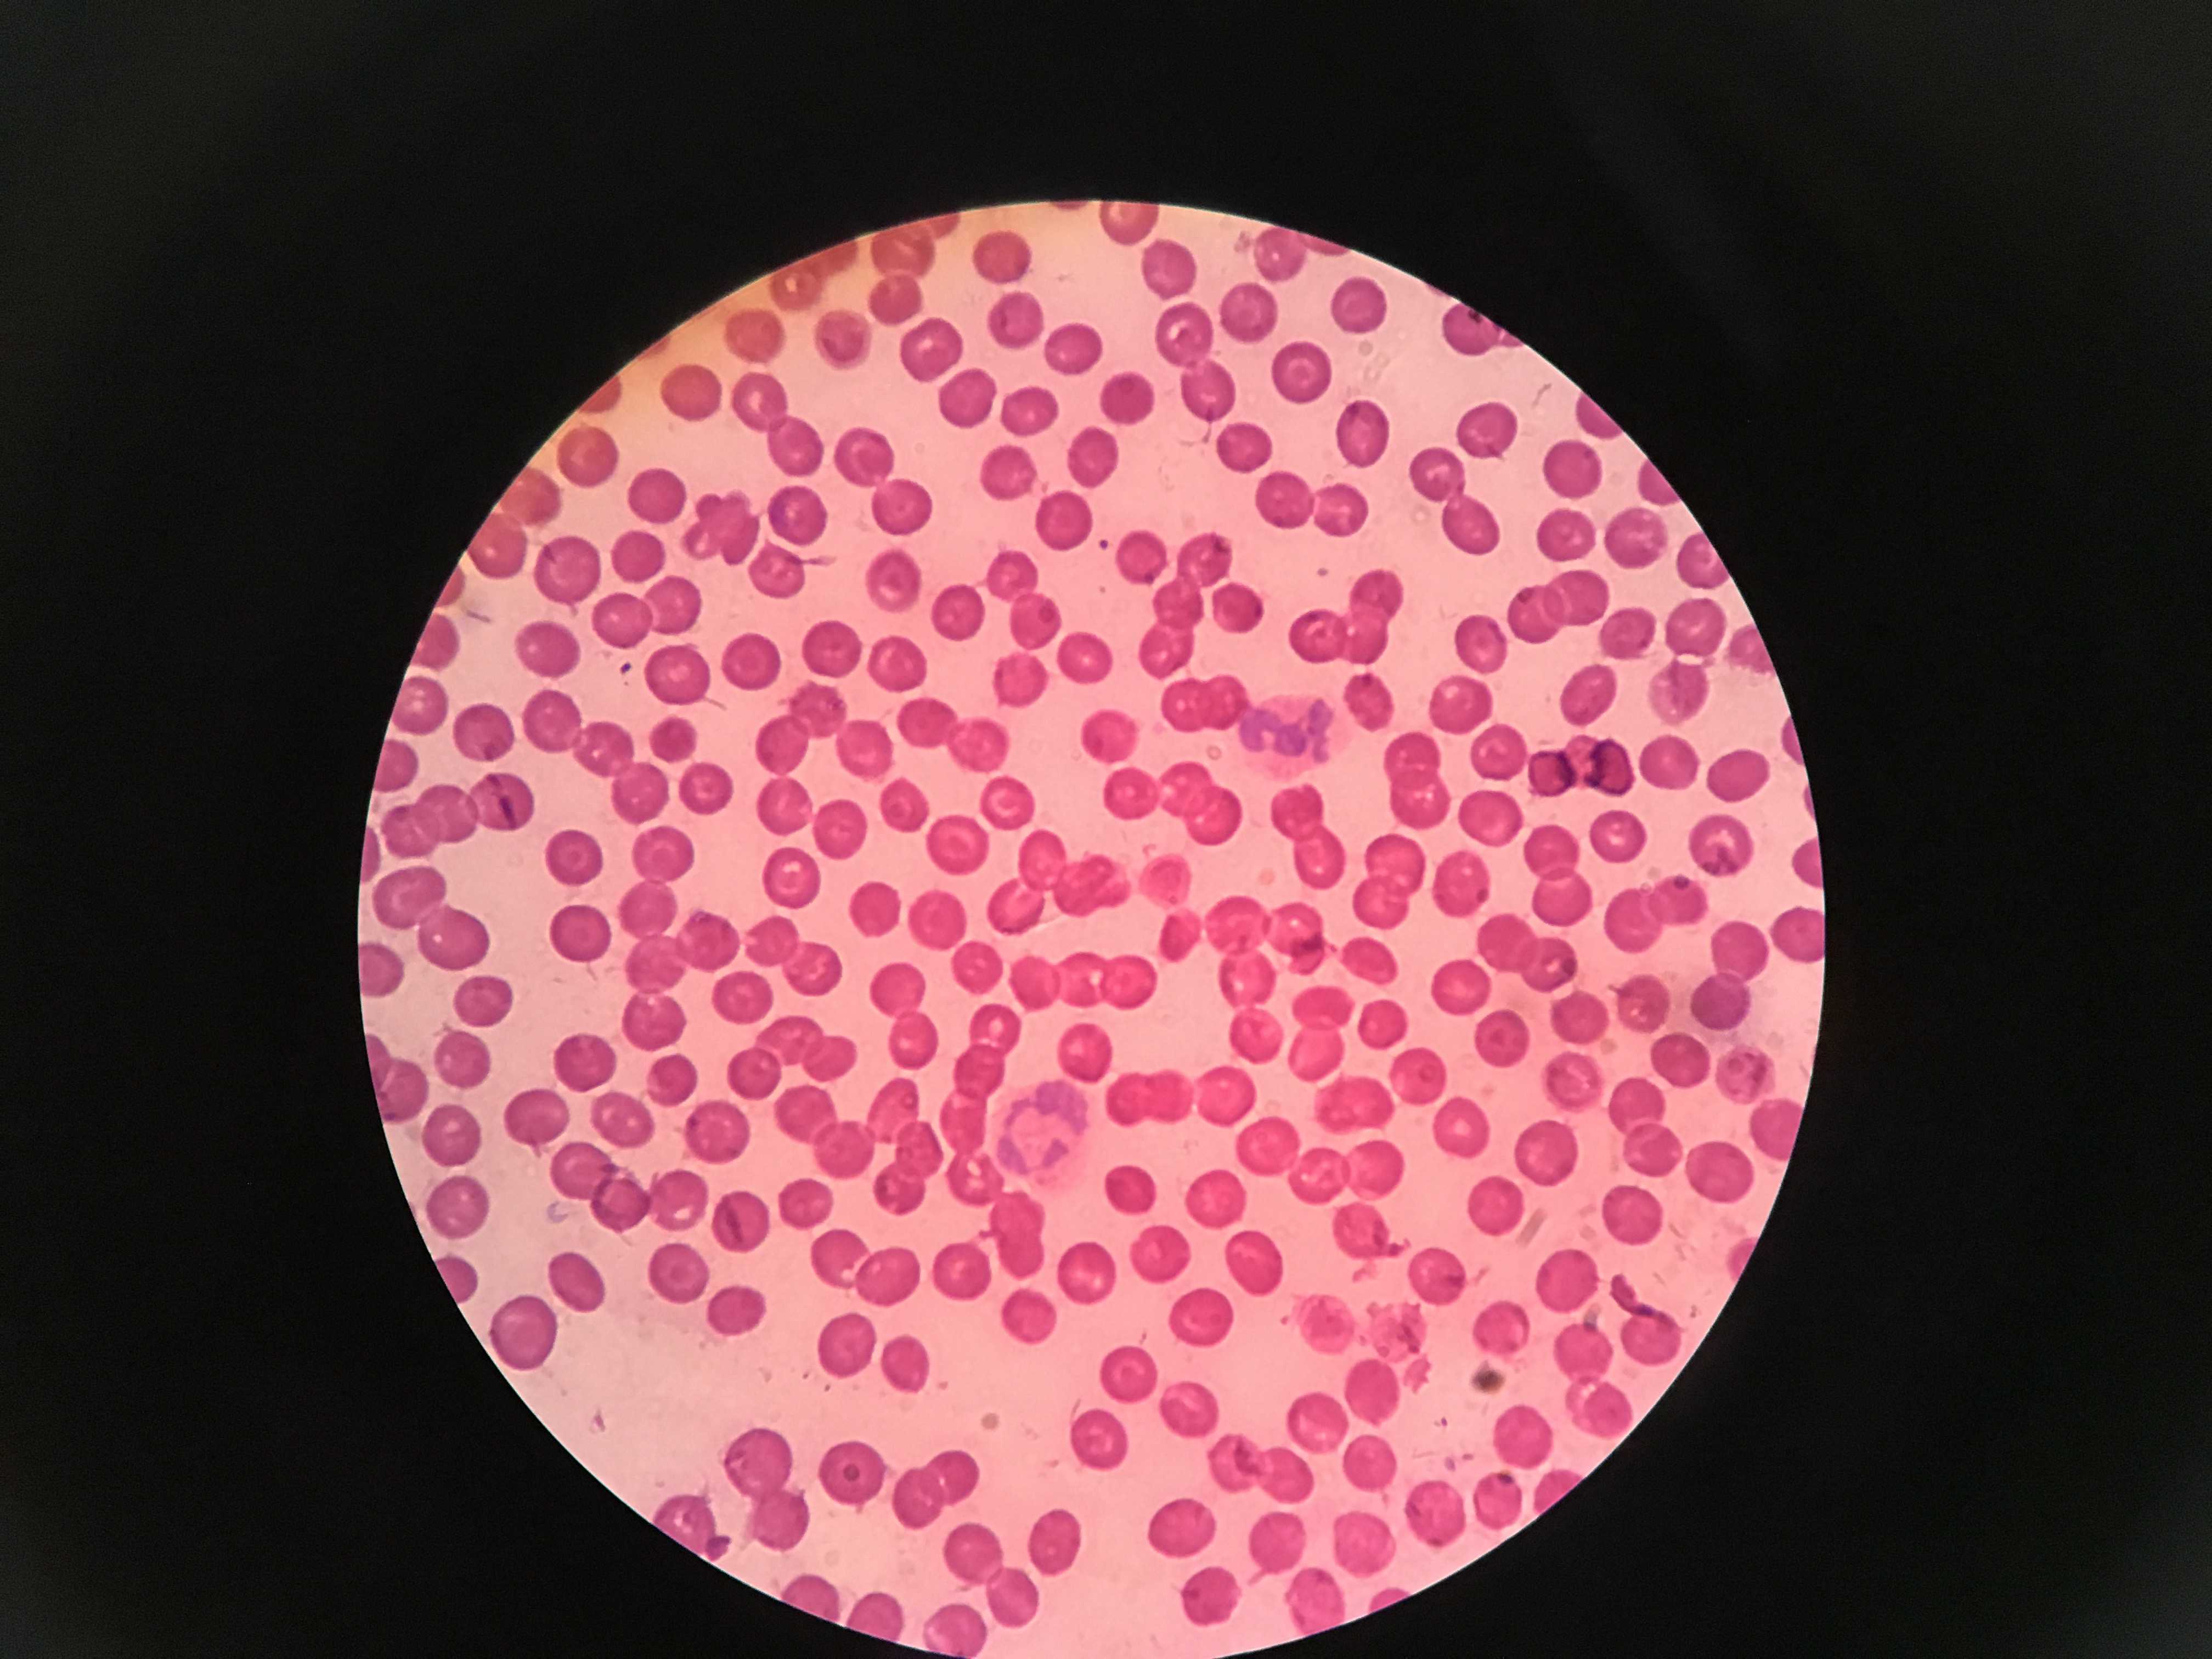

Collection of random photos from my archives.

- 2025-12-20

- 2025-12-19

- 2025-12-17

- 2025-12-16

- 2025-12-11

- 2025-12-05

- 2025-11-26

- 2025-11-26

- 2025-11-20

- 2025-11-19

- 2025-11-18

- 2025-11-17

- 2025-11-15

- 2025-11-15

- 2025-11-08

- 2025-11-08

- 2025-11-05

- 2025-11-02

- 2025-11-01

- 2025-11-01

- 2025-10-31

- 2025-10-31

- 2025-10-30

- 2025-10-30

- 2025-10-24

- 2025-10-20

- 2025-10-19

- 2025-10-13

- 2025-10-12

- 2025-10-11

- 2025-10-09

- 2025-10-06

- 2025-10-05

- 2025-10-04

- 2025-10-02

- 2025-09-28

- 2025-09-15

- 2025-09-13

- 2025-09-09

- 2025-09-06

- 2025-09-03

- 2025-08-22

- 2025-08-20

- 2025-08-20

- 2025-08-19

- 2025-08-19

- 2025-08-18

- 2025-08-16

- 2025-08-16

- 2025-08-14

- 2025-08-12

- 2025-08-11

- 2025-08-10

- 2025-08-10

- 2025-08-09

- 2025-08-09

- 2025-08-08

- 2025-08-06

- 2025-08-03

- 2025-07-31

- 2025-07-26

- 2025-07-20

- 2025-07-16

- 2025-07-16

- 2025-07-16

- 2025-07-15

- 2025-06-28

- 2025-06-26

- 2025-06-21

- 2025-06-13

- 2025-06-13

- 2025-06-08

- 2025-05-31

- 2025-05-27

- 2025-05-24

- 2025-05-17

- 2025-04-30

- 2025-04-21

- 2025-04-21

- 2025-04-07

- 2025-04-03

- 2025-03-22

- 2025-03-18

- 2025-03-16

- 2025-03-15

- 2025-03-14

- 2025-03-08

- 2025-02-26

- 2025-02-22

- 2025-02-15

- 2025-02-08

- 2025-02-05

- 2025-02-03

- 2025-01-28

- 2025-01-26

- 2025-01-18

- 2025-01-10

- 2025-01-04

- 2025-01-03

- 2024-12-24

- 2024-12-24

- 2024-12-20

- 2024-12-17

- 2024-12-12

- 2024-12-08

- 2024-11-14

- 2024-11-08

- 2024-11-05

- 2024-10-18

- 2024-10-05

- 2024-10-01

- 2024-09-04

- 2024-08-23

- 2024-08-09

- 2024-07-29

- 2024-07-29

- 2024-07-26

- 2024-07-24

- 2024-07-21

- 2024-07-21

- 2024-07-20

- 2024-07-20

- 2024-07-19

- 2024-07-17

- 2024-07-17

- 2024-07-17

- 2024-07-17

- 2024-07-16

- 2024-07-15

- 2024-07-15

- 2024-06-15

- 2024-06-11

- 2024-06-05

- 2024-06-02

- 2024-05-24

- 2024-05-12

- 2024-05-11

- 2024-05-06

- 2024-05-06

- 2024-05-06

- 2024-05-05

- 2024-05-05

- 2024-05-04

- 2024-05-04

- 2024-05-01

- 2024-05-01

- 2024-04-06

- 2024-04-06

- 2024-03-10

- 2024-01-26

- 2024-01-26

- 2024-01-23

- 2023-12-31

- 2023-12-28

- 2023-12-02

- 2023-11-21

- 2023-10-19

- 2023-09-05

- 2023-08-26

- 2023-08-01

- 2023-07-28

- 2023-07-28

- 2023-07-28

- 2023-07-26

- 2023-07-23

- 2023-07-23

- 2023-07-23

- 2023-05-28

- 2023-04-09

- 2023-03-28

- 2023-02-25

- 2023-02-15

- 2023-02-14

- 2023-01-16

- 2022-12-17

- 2022-09-03

- 2022-08-14

- 2022-08-02

- 2022-07-09

- 2022-01-23

- 2022-01-23

- 2022-01-01

- 2021-12-31

- 2021-12-03

- 2021-08-05

- 2021-07-25

- 2021-06-30

- 2021-06-20

- 2021-06-19

- 2021-05-02

- 2021-04-18

- 2020-10-24

- 2020-09-09

- 2020-06-18

- 2019-10-16

- 2019-05-03

- 2019-04-20

- 2019-04-15

- 2019-03-02

- 2019-02-22

- 2019-02-09

- 2019-01-21

- 2019-01-09

- 2018-12-22

- 2018-12-21

- 2018-12-14

- 2018-10-31

- 2018-10-24

- 2018-10-22

- 2018-10-21

- 2018-10-20

- 2018-10-17

- 2018-10-13

- 2018-10-11

- 2018-10-01

- 2018-09-16

- 2018-09-08

- 2018-09-08

- 2018-09-04

- 2018-04-27

- 2018-03-31

- 2018-03-11

- 2018-02-25

- 2018-02-13

- 2018-02-09

- 2017-10-18

- 2017-10-04

- 2017-08-15

- 2017-06-15

- 2017-04-07

- 2017-04-07

- 2017-01-27

- 2016-11-28

- 2016-09-15

- 2016-08-09

- 2016-07-06

- 2016-06-18

- 2016-06-06

- 2016-02-22

- 2016-01-02

- 2016-01-01

- 2015-12-27

- 2015-12-26

- 2015-12-25

- 2015-10-24

- 2015-06-08

- 2015-06-01

- 2015-04-24

- 2015-03-21

- 2015-02-28

- 2015-01-10

- 2014-12-31

- 2014-07-20

- 2014-07-20

- 2014-07-19

- 2014-07-19

- 2014-07-18

- 2014-07-16

- 2014-05-03

- 2014-05-01

- 2014-02-28

- 2014-02-27

- 2013-09-14

- 2013-08-12

- 2013-05-19

- 2013-02-21

- 2012-12-29

- 2012-12-27

- 2012-10-26

- 2012-10-26

- 2012-07-31

- 2012-06-12

- 2012-04-14

- 2011-11-17

- 2011-11-16

- 2011-09-10

- 2011-07-24

- 2011-07-23

- 2011-07-22

- 2011-07-22

- 2011-07-19

- 2011-07-18

- 2010-10-17

- 2010-10-16

- 2008-10-11

- 2008-10-11

- 2008-10-11